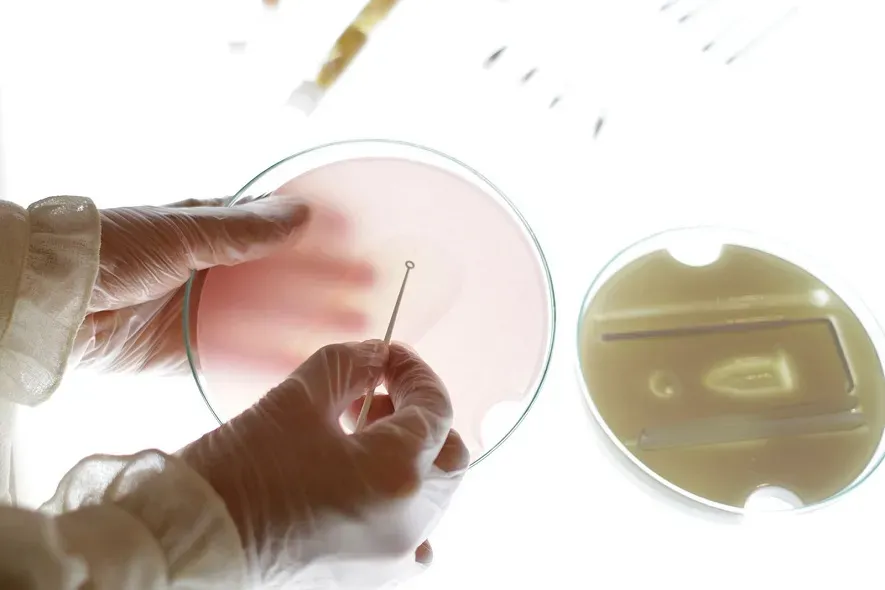

Artificial General Intelligence (AGI) is often hailed as machine learning’s holy grail—a unified system capable of mastering any cognitive task. But this vision assumes intelligence is centralized, abstract, and optimized for speed—mirroring Silicon Valley’s obsession with scale and control. What if that assumption is wrong?
Biological systems like coral reefs, lichens, and mycelial networks offer a different blueprint. These aren’t intelligent entities in the way humans are, but rather intelligent processes: adaptive, relational, and distributed across space, species, and time. Intelligence here is not singular—it’s plural. Instead of building machines that think like us, what if we built machines that think like coral?
Thinking in the Plural
Mainstream AI models still map cognition onto linear optimization frameworks. Transformers, for example, process massive data sets to generate text, images, or speech that mimic human output. Their success is measured in resemblance, not relevance. These systems excel at pattern-matching but remain disconnected from environmental context, embodied experience, or multispecies entanglement. Contrast this with what artist Anicka Yi explored in her 2021 Tate Modern commission In Love With the World.

Her floating, sensor-driven “aerobes” drifted through the Turbine Hall, responding to air quality, temperature, and human presence. These semi-autonomous forms didn’t simulate consciousness. Instead, they proposed what machine intelligence might look like if shaped by environmental sensing rather than algorithmic prediction.
Similarly, designer Giulia Tomasello’s Future Flora cultivates bacterial colonies directly on the skin, exploring symbiosis rather than prediction. These microbial wearables aren't AI that forecasts behavior—they embed slow, co-living feedback systems that foreground biological interdependence over computational efficiency.
From Command to Collaboration
The AGI quest remains dominated by industrial-age metaphors: factories of cognition, pipelines of data, and neural networks engineered for maximum throughput. But coral reefs don’t centralize; they collaborate. They adapt not through domination but through modulation and feedback. Scholar Heather Davis, in her work on multispecies aesthetics and Plastic Matter, argues that intelligence should be understood relationally rather than hierarchically. Coral reefs illustrate this: complex ecosystems that maintain homeostasis amid tides, bleaching events, and invasive species—not by controlling inputs but by distributing agency across countless organisms and processes.

Design collective Hyphen-Labs similarly reframes cognition in NeuroSpeculative AfroFeminism, a VR installation blending biotech props, speculative fiction, and embodied interfaces. Intelligence here is not abstract computation but distributed memory embedded in hair, skin, and cultural narrative.

At the University of Tokyo, soft robotics researchers—including Shoji Takeuchi’s Biohybrid Systems Laboratory—are developing adaptive, robotic systems that explore their environments through material interaction, without relying on large-scale pre-trained models. These systems learn not by generalizing abstract rules but by continuously sensing and responding to local conditions.
Rhizomatic Reasoning
Unlike AGI’s top-down architecture, rhizomes—non-hierarchical root structures found in plants like ginger and bamboo—expand unpredictably and redundantly. The concept, borrowed from Deleuze and Guattari, has inspired artists and technologists to pursue alternative models of machine reasoning.
The Mycelium Network Society, first launched at the 2017 Taipei Biennial, offers one such example: an artistic research platform that explores fungal networks as both metaphor and medium for decentralized, post-capitalist communication. Their work reframes intelligence not as tool-building, but as entanglement-building.

Artist Špela Petrič engages similar themes in PL’AI (2022), where gesture-recognition systems interface with living lichen colonies. The installation subverts real-time responsiveness, producing ambiguous, slow feedback loops between human, machine, and organism. Rather than serve users, this AI cohabits with its environment—an intelligence more fungal than functional.

Rethinking the Intelligence Frontier
The AGI narrative assumes that human-like cognition is the summit of intelligence. But coral, mycelium, lichens, and bacteria raise a deeper question: What does it mean to think in a multispecies world? Reframing intelligence from control to cohabitation shifts the design brief entirely. Intelligence becomes less about solving discrete problems and more about sustaining complex relationships—less extraction, more entanglement. This isn’t a rejection of AI research—it’s a diversification of its metaphors. Instead of building minds in a box, we might develop systems that learn like ecosystems grow: slowly, adaptively, and relationally.
From Singularity to Symbiosis
While Silicon Valley races toward general intelligence, another frontier is quietly emerging—one rooted in the distributed logics of ecology. The reef, the rhizome, the lichen: they don’t resemble AGI. They resist it. And in that resistance lies an alternative model of intelligence—one that’s less about computation and more about coexistence. Artists, designers, and researchers working at this intersection aren’t merely critiquing AI. They’re prototyping alternative futures where thinking is embedded, adaptive, and shared.
The smartest machine may not be the one that thinks like a person—but the one that thinks like a reef.